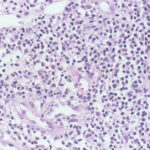

Mycobacteria marinum =متفطرات حوض السباحة
|
Infections with Nontuberculosis Mycobacteria Among the nontuberculosis, nonleprosy mycobacterial infections of the skin, those caused by M. marinum are the most common among nonimmunosuppressed people . Unlike M. tuberculosis, which is transmitted from person to person, nontuberculosis mycobacteria are abundant in nature, in soil and water, and contact is frequent in most zones of the world . |
|
These skin infections may be acquired by direct inoculation into the skin or by hematogenous spread from a visceral focus. Increased use of immunosuppression in medicine (e.g., for transplantation and cancer chemotherapy) and the pandemic of HIV/AIDS have resulted in many more mycobacterial skin infections. The cellmediated immune system is a major defense against such organisms and is affected or destroyed during the course of these immunosuppressive conditions. The clinical and histopathologic patterns are also altered, with organisms being found in greater density than in immunocompetent persons. |
|
The histopathologic picture in nontuberculosis mycobacterioses is just as variable as the clinical picture and may present nonspecific acute and chronic inflammation, suppuration and abscess formation, or tuberculoid granulomas with or without caseation . In some instances, both tissue reactions occur concurrently. The presence or absence of acid-fast bacilli depends on the tissue reaction. In suppurative lesions, numerous acidfast bacilli often can be found. |
|
Infection with Mycobacterium Kansasii M. kansasii is usually a lymph node and pulmonary infection, and skin lesions are unusual. Implantation causes a chronic cutaneous nodule and sometimes ulceration . The lesions are often crusted. There may be sporotrichoid lymphatic spread of lesions up the extremity . In immunocompromised patients, such as those with HIV infection, there may be multiple visceral lesions (lung and bone) with hematogenous dissemination to skin. The skin lesions are acute abscesses with large numbers of acid-fast bacilli . |
|
Infection with Mycobacterium Avium-intracellulare M. avium complex infection is a common cause of cervical lymph node mycobacteriosis in normal children and of pulmonary disease in previously damaged lungs . Prior to the HIV pandemic, skin infections were rare, with hematogenously borne lesions in skin and subcutis observed in patients usually with immunosuppressing diseases . |
|
Severely immunocompromised patients, such as those with HIV infection, have a very high prevalence of M. aviumintracellulare bacteremia , and many show one or more cutaneous papules and nodules . Steroid therapy also predisposes to skin lesions. The histology may be granulomatous or mixed acute and chronic inflammatory, as with tuberculosis . Sometimes, there is a histology resembling that of lepromatous leprosy .Macrophages contain large numbers of bacilli without necrosis, and a spindle cell transformation of macrophages, forming a histoid-like lesion (as in leprosy), can occur . |
|
Infection with Mycobacterium Marinum Infections with M. marinum can be contracted through minor abrasions incurred while bathing in swimming pools or in ocean or lake water or while cleaning home aquariums . Infected swimming pools have caused epidemics, the largest of |
|
which affected 290 persons . The period of incubation usually is about 3 weeks but may be longer . |
|
Clinically, most of the lesions caused by M. marinum are solitary and consist of indolent, dusky red, hyperkeratotic, papillomatous papules, nodules, or plaques. Superficial ulceration is occasionally observed. The fingers, knees, elbows, and feet are most commonly affected. In some instances, satellite papules arise and ascending sporotrichoid spread occurs Lesions may form at different sites in the case of multiple injuries. Although spontaneous healing usually takes place within a year, the lesions persist in some patients for many years. A few HIV-associated cases have been reported . Fatal disseminated M. marinum infection is rare . |
|
Histopathology. Early lesions no more than 2 or 3 months old show a nonspecific inflammatory infiltrate composed of neutrophils, monocytes, and macrophages. In lesions about 4 months old, a few multinucleated giant cells and a few small epithelioid cell granulomas usually are present, and in lesions 6 months old or older, typical tubercles or tuberculoid structures may be seen (126). Areas of necrosis are only occasionally present in the centers of the granulomas. The epidermis often shows marked hyperkeratosis with an acute inflammatory infiltrate and ulceration . |
|
Acid-fast bacilli usually can be identified in histologic sections of early lesions that show a nonspecific inflammatory infiltrate. In contrast, tuberculoid granulomas generally no longer show acid-fast organisms unless areas of central necrosis are present. Although primary lesions usually require a few months for the formation of tuberculoid granulomas, the sporotrichoid nodules that arise later show tuberculoid granulomas and a lack of acidfast bacilli even when they have been present for only a few weeks. |
|
Differential Diagnosis. The granulomatous reaction produced by M. marinum is similar to that observed in tuberculosis verrucosa cutis or lupus vulgaris. The pattem of pseudoepitheliomatous hyperplasia with granulomas and polymorphonuclear neutrophil infiltrate is also seen in several cutaneous mycoses (e.g., sporotrichosis and chromoblastomycosis), so fungal stains need to be examined alongside Ziehl-Neelsen stains. For definitive identification, culture may be necessary. |
|
Buruli Ulcer (Mycobacterium ulcerans) Buruli ulceration, an infection caused by a nontuberculosis mycobacterium, M. ulcerans, is endemic in West and |
|
Central Africa, Central America, and South Australia . The organism is now identified in nature, near inland water and rivers, and is directly implanted or follows an aquatic insect bite. The infection commences as a palpable cutaneous nodule. In some cases, this may heal but more usually progresses to ulceration of the skin with extensive undermining of the epidermis and extension of the necrosis down to fascia and even bone . These painless ulcers are usually located on extremities and buttocks, but trunk and facial ulcers also occur. |
|
Histopathology. The infection begins as a subcutaneous nodule exhibiting "ghost" ischemic-type dermal collagen and fat necrosis with deposition of fibrin and hematoxyphilic extracellular clumps of mycobacteria. Ulceration proceeds as the epidermis loses its vascular supply. Ziehl-Neelsen stains reveal vast numbers of acid-fast bacilli in the necrotic fat ; their distribution is often irregular. A variable degree of neutrophil infiltration and thrombosis of vessels are also observed. In time, a nonspecific granulation tissue or a granulomatous reaction commences from the depth and sides of the ulcer; healing and re-epithelialization take place with considerable scarring. Acid-fast bacilli decline rapidly in number during healing . The histopathologic case definition for Buruli ulcer, useful for research studies, is (a) the typical pattern of infarctivelike necrosis of deep dermal collagen and fat and (ideally, but not always found in limited samples) (b) nearby clusters of acid-fast bacilli. |
|
Pathogenesis The widespread necrosis of subcutaneous tissue is caused by a toxin secreted by M. ulcerans, a pathogenesis unique to this species of mycobacteria. It is polyketide mycolactone, and strain and geographical differences in mycolactone virulence are already described (the disease is less severe in Australia than in central Africa, related to different mycolactone strains). This toxin causes necrosis when inoculated into guinea pig skin and into macrophages in tissue culture . Like M. marinum, M. ulcerans shows optimal cultural growth at 3D· to 33·C. |
|
PCR technology has been used to track the distribution of M. ulcerans in Buruli ulcer lesions and to compare the mycobacterial burden with histopathologic changes . While peaks of mycobacterial DNA and histopathologically recognized acid-fast bacilli in the necrotic base of the ulcers marked the position of the primary infection focus, mycobacterial DNA (and sometime microcolonies) was also present in samples from the periphery of the ulcers and occasionally from macroscopically and histologically healthy-looking excised tissue margins and in sites where satellite lesions were developing. Even when granulomas provided evidence for the development of cell-mediated immunity, development of satellite lesions by contiguous spreading was not completely prevented. |
|
Healing of Buruli ulcer coincides with development of delayed hypersensitivity to the mycobacterium, possibly contingent on the cessation of mycolactone production. In a recent study, expression of cytokines was correlated with the inflammatory response evaluated by histopathology . All of the cases showed extensive necrosis and chronic inflammation. The most important feature correlating with chronicity was considered to be the presence or absence of granulomas coexisting with a mixed proinflammatory/antiinflammatory cytokine balance. Granulomas were absent from relatively early ulcerative lesions, which contained more bacilli and little interferon (IFN}-gamma, suggesting that at this stage of the disease strong suppression of the protective cellular immune response facilitates proliferation of bacilli. When granulomas were present, significantly higher expression of IFN-gamma was seen as well as lower bacillary counts. |